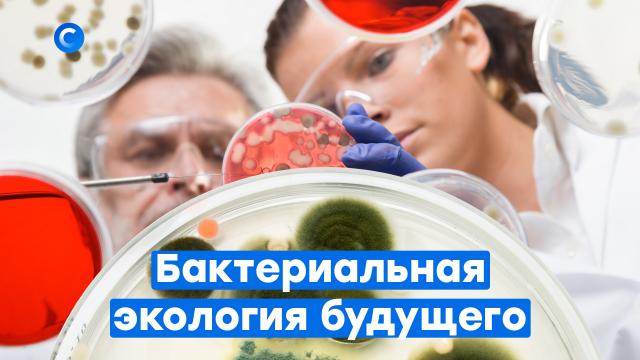

Ученые во всем мире изучают и разрабатывают новые способы утилизации отходов. В частности, они предлагают перерабатывать бытовой мусор с помощью бактерий. В естественных условиях органика разлагается от полугода до нескольких лет, а микроорганизмы способны переработать пищевые отходы за месяц. В некоторых регионах России уже появились специальные комплексы, где для утилизации мусора используют бактерий.
Первый в своем роде отечественный «химический пастух» — уникальная разработка ученых Московского университета нефти и газа совместно с Институтом нефтехимического синтеза академии наук. Особые реагенты на основе органических соединений, то есть безопасные для окружающей среды, моментально сгоняют нефтепродукты в один комок, который легко убирается и не оставляет следов загрязнения.
Если столичные специалисты пока только ищут инвесторов для полномасштабных испытаний, то микробиологи Томского университета уже протестировали свою разработку в природных условиях. Их «Абориген» — это тоже препарат для биологической очистки водоемов от нефти. Специально отобранные микроорганизмы используют углеводороды в качестве пищи и источника энергии, окисляя нефтепродукты и превращая их в нетоксичные вещества.
«Абориген» уже успешно применяют в Казахстане, утилизируя нефтепродукты даже из почвы. А летом 2021 года микробы потрудились в Республике Коми, уменьшив в рамках совместного проекта с российской нефтяной компанией содержание нефти в водоеме в 65 раз.
В Петербурге одноклеточные водоросли, то есть те же микроорганизмы, научили перерабатывать отходы в биодизель, то есть не просто в
Но если справиться с цветением воды и даже нефтяными пятнами без угрозы для окружающей среды ученым уже вполне по силам, то полимеры и пластики победить